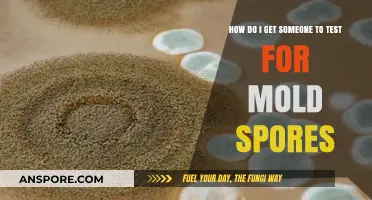
Effective Ways to Encourage Mold Spore Testing in Your Home

In the expansive universe of *Spore*, encountering and befriending the Grox, a formidable and advanced alien species, can be a challenging yet rewarding endeavor. The Grox are known for their aggressive nature and dominance in the galaxy, making them a significant obstacle for players aiming to explore and thrive. To successfully befriend them, players must employ a combination of strategic diplomacy, careful resource management, and a deep understanding of the game’s mechanics. This involves mastering the use of the Sporepedia, leveraging alliances with other species, and utilizing advanced technology to communicate and negotiate with the Grox. By approaching them with caution and creativity, players can turn a potential adversary into a powerful ally, unlocking new opportunities for galactic exploration and cooperation.
| Characteristics | Values |
|---|---|
| Game | Spore |
| Species | Grox |
| Alignment | Initially Aggressive |
| Friendship Method | Requires careful strategy and specific actions |
| Key Steps | 1. Avoid direct confrontation initially. 2. Use the "Sing" tool to communicate peacefully. 3. Offer gifts (food or spices) to improve relations. 4. Gradually build trust through non-aggressive interactions. 5. Use the "Grox Beacon" if available to signal peaceful intentions. |
| Difficulty | High, due to Grox's naturally hostile nature |
| Outcome | Successful friendship can lead to alliances and access to Grox technology |
| Additional Tips | - Save frequently during attempts. - Be patient and persistent. - Avoid provoking them with aggressive actions. |
Explore related products
What You'll Learn
- Understanding Grox Behavior: Learn their patterns, aggression levels, and territorial habits to predict their actions
- Diplomacy Strategies: Use gifts, alliances, and trade to build trust and avoid conflict with the Grox
- Military Tactics: Equip advanced weapons, use hit-and-run, and exploit their weaknesses in battles
- Empire Expansion: Colonize planets near Grox space cautiously, fortifying borders to deter invasions
- Technology Edge: Research key techs like stealth, shields, and FTL to outmaneuver and defend against them

Understanding Grox Behavior: Learn their patterns, aggression levels, and territorial habits to predict their actions
The Grox in *Spore* are notorious for their aggressive behavior, but understanding their patterns can turn a confrontation into a calculated interaction. Observing their movement reveals a predictable rhythm: they patrol their territory in a clockwise or counterclockwise loop, often returning to a central point. This pattern becomes exploitable once you identify their starting and ending locations. For instance, if a Grox ship begins its patrol near a planet’s equator, it’s likely to follow a circular path along the same latitude. Use this to your advantage by positioning yourself just outside their detection range, allowing you to study their aggression levels without triggering an attack.
Aggression levels in Grox are not static; they escalate based on proximity and perceived threats. A Grox ship will typically ignore you if you maintain a distance of at least 50 units, but encroaching within 30 units will provoke a warning shot. Crossing the 20-unit threshold guarantees an attack. However, their aggression resets after 10 seconds of disengagement, providing a window to retreat and reassess. Experiment with this by hovering at the 30-unit mark to gauge their reaction speed and accuracy, which varies depending on their ship type. For example, Grox scouts are faster but less accurate, while destroyers are slower but deal more damage.
Territorial habits are the key to predicting Grox actions. Each Grox system has a "core world," usually the planet closest to the center of the system, which they defend most fiercely. Secondary planets have smaller patrol ranges, typically limited to a 100-unit radius around the planet. Mapping these boundaries allows you to navigate safely by sticking to the edges of their territory. A practical tip: use the game’s galaxy view to identify systems with fewer Grox-controlled planets, as these often have less stringent patrols and provide safer routes for exploration or trade.
To effectively "fraind" the Grox, combine pattern recognition with strategic timing. For instance, Grox ships refuel at their core world every 5 minutes, leaving a 30-second window where they’re stationary and less alert. Use this moment to approach cautiously, offering gifts like Spice or rare artifacts to reduce hostility. However, avoid overstaying your welcome—Grox patience lasts only 10 seconds after refueling. Pair this tactic with knowledge of their patrol routes to minimize risk. By mastering these behaviors, you transform the Grox from an insurmountable threat into a predictable, even manageable, adversary.
Fungi's Spore Reproduction: How Do They Multiply and Spread?
You may want to see also

Diplomacy Strategies: Use gifts, alliances, and trade to build trust and avoid conflict with the Grox
In the vast universe of Spore, the Grox are often seen as formidable adversaries, but with the right diplomacy strategies, you can transform them from foes to allies. The key lies in leveraging gifts, alliances, and trade to build trust and avoid unnecessary conflict. By understanding their behavior and preferences, you can navigate interactions with the Grox effectively, ensuring a peaceful coexistence or even a mutually beneficial partnership.
Step 1: Master the Art of Gift-Giving
The Grox, despite their fearsome reputation, are not immune to gestures of goodwill. Start by offering them resources they value, such as Spice or rare artifacts. Spice, in particular, is a highly prized commodity in Grox society, and gifting it can significantly improve relations. Begin with small quantities—around 100–200 units—to gauge their response. Over time, increase the amount as trust grows, but avoid overwhelming them, as excessive generosity can be misinterpreted. Pair gifts with friendly actions, such as avoiding their space or assisting in minor conflicts, to reinforce your intentions.
Step 2: Forge Strategic Alliances
Allying with the Grox requires careful planning and timing. Before approaching them, ensure you have a strong empire with a robust military and economy. Weakness can be misinterpreted as vulnerability, inviting aggression rather than respect. Begin by allying with neighboring empires that are already on good terms with the Grox. This creates a network of trust and demonstrates your ability to cooperate. Once you’ve established these alliances, propose a non-aggression pact with the Grox, emphasizing mutual benefits. Highlight shared enemies or threats to frame the alliance as a logical step toward stability.
Step 3: Engage in Balanced Trade
Trade is a cornerstone of diplomacy with the Grox. They are pragmatic and value transactions that benefit both parties. Start by offering resources they lack, such as rare minerals or advanced technology, in exchange for Spice or military support. Avoid one-sided trades, as the Grox will quickly lose interest if they perceive no value. Use the trade interface to negotiate terms, ensuring fairness and transparency. Over time, establish regular trade routes to solidify the relationship. This not only builds trust but also integrates your economies, making conflict less likely.
Cautions and Considerations
While these strategies are effective, they are not without risks. The Grox are unpredictable, and their responses can vary based on their mood or the state of their empire. Always monitor their behavior during interactions, and be prepared to adjust your approach if they show signs of aggression. Avoid provoking them by encroaching on their territory or attacking their allies. Additionally, be cautious when allying with other empires against the Grox, as this can escalate tensions and lead to retaliation.
Diplomacy with the Grox is a delicate but rewarding endeavor. By combining thoughtful gift-giving, strategic alliances, and balanced trade, you can transform a potential adversary into a valuable ally. Remember, consistency and respect are key. Over time, these efforts will not only prevent conflict but also open doors to new opportunities in the Spore galaxy. With patience and persistence, even the most fearsome empires can become trusted partners.
Milky Spore's Impact: Does It Harm Lightning Bugs in Your Garden?
You may want to see also

Military Tactics: Equip advanced weapons, use hit-and-run, and exploit their weaknesses in battles
In the vast universe of Spore, encountering the Grox can be a daunting experience, especially for players who are unprepared for their aggressive nature. To effectively counter these formidable foes, a well-thought-out military strategy is crucial. One proven approach involves equipping your spacecraft with advanced weapons, employing hit-and-run tactics, and exploiting the Grox's weaknesses in battle. This method not only minimizes your losses but also maximizes the damage inflicted on the enemy.
Equipping advanced weapons is the first step in gaining an edge over the Grox. In Spore, weapon upgrades can be obtained through research and development, which requires gathering and analyzing alien artifacts. Focus on acquiring plasma cannons, photon torpedoes, and other high-damage weapons that can pierce through the Grox's defenses. For instance, the Plasma Burst Cannon, unlocked at the Epic level, deals massive area-of-effect damage, making it ideal for weakening large Grox fleets. Pairing these weapons with defensive upgrades like shields and armor ensures your spacecraft can withstand counterattacks while delivering devastating blows.
Hit-and-run tactics are essential for conserving resources and avoiding prolonged engagements with the Grox. The strategy involves striking quickly, inflicting maximum damage, and then retreating to a safe distance to regroup and repair. To execute this effectively, position your spacecraft at the edge of the Grox's detection range, launch a surprise attack, and immediately disengage. Use the game's speed boost feature to create distance between your ship and the enemy fleet. This method is particularly effective when combined with stealth technology, which allows you to remain undetected while planning your next strike.
Exploiting the Grox's weaknesses is the key to turning the tide of battle in your favor. Observing their combat patterns reveals that they often rely on brute force rather than strategic maneuvering. Take advantage of this by targeting their larger, slower ships first, as these are typically the most vulnerable. Additionally, the Grox's reliance on energy-based weapons means they are susceptible to electromagnetic pulse (EMP) attacks, which can disable their shields and weapons temporarily. Incorporating EMP devices into your arsenal can create opportunities for decisive strikes.
In practice, combining these tactics requires careful planning and execution. Start by upgrading your spacecraft with a balanced mix of offensive and defensive tools. During battles, prioritize hit-and-run strikes on weaker Grox vessels while avoiding direct confrontations with their flagship. Use EMP attacks to neutralize their defenses before moving in for the kill. Remember, the goal is not to engage in a war of attrition but to outmaneuver and outsmart the Grox. By mastering these military tactics, you can not only survive encounters with the Grox but also dominate them, paving the way for galactic conquest in Spore.
Cold Spores Inoculation: Unlocking Benefits and Safety Considerations
You may want to see also

Empire Expansion: Colonize planets near Grox space cautiously, fortifying borders to deter invasions
Expanding your empire near Grox space in *Spore* is a high-risk, high-reward endeavor. The Grox, a formidable and aggressive alien race, control a vast swath of the galaxy, and their territory is notoriously difficult to infiltrate. To succeed, you must balance ambition with caution, prioritizing strategic colonization and robust border defenses. Begin by identifying planets on the periphery of Grox space that offer valuable resources or strategic advantages. These planets will serve as your footholds, but their proximity to the Grox demands meticulous planning and fortification.
The first step in this expansion is to assess the Grox’s activity patterns. Observe their fleet movements, attack frequencies, and resource extraction habits. Use this intelligence to determine the safest entry points and timing for colonization. For instance, if the Grox frequently patrol a particular sector, consider establishing your colonies in less-traveled regions or during periods of reduced Grox activity. Once a planet is colonized, immediately deploy defensive structures such as turrets, shields, and resource-gathering buildings to ensure self-sufficiency and resilience against potential attacks.
Fortifying borders is not just about building defenses; it’s about creating a deterrent. The Grox are less likely to invade if the cost of attack outweighs the potential gain. Invest in advanced weaponry and defensive technologies, such as plasma turrets and planetary shields, to make your colonies unappealing targets. Additionally, maintain a fleet of spacecraft near the border to respond swiftly to any Grox incursions. A well-defended border not only protects your colonies but also buys you time to mobilize reinforcements or negotiate alliances with neighboring empires.
A comparative analysis of successful Grox-adjacent empires reveals a common strategy: gradual expansion coupled with diplomatic efforts. While the Grox are hostile, they are not invincible. By colonizing planets incrementally and fortifying each new territory, you reduce the risk of overwhelming retaliation. Simultaneously, consider engaging in limited trade or alliances with other empires near Grox space. These alliances can provide additional military support or intelligence, further bolstering your defenses. Remember, the goal is not to provoke the Grox but to coexist and expand without triggering a full-scale war.
Finally, always have an exit strategy. Despite your best efforts, the Grox may launch a large-scale invasion. Prepare evacuation protocols for your colonies, ensuring that critical resources and populations can be relocated quickly. Store backup save files or use in-game features to revert to a safer state if necessary. Empire expansion near Grox space is a game of patience and adaptability—success hinges on your ability to fortify, strategize, and respond to the ever-present Grox threat.
Does Healing Return Affect Saryn's Spores in Warframe?
You may want to see also

Technology Edge: Research key techs like stealth, shields, and FTL to outmaneuver and defend against them
In the vast, procedurally generated universe of *Spore*, encountering the Grox—a hostile, empire-building species—can be a daunting experience, especially for unprepared players. To turn the tide in your favor, leveraging advanced technologies becomes paramount. Stealth, shields, and faster-than-light (FTL) travel are not just tools; they are the pillars of survival and dominance. Each technology serves a distinct purpose, and mastering their use can transform you from a Grox target into a formidable adversary.
Stealth technology is your first line of defense. By reducing your empire’s visibility, you minimize the chances of Grox detection, allowing you to expand and fortify without drawing immediate aggression. Invest in stealth early, particularly during the Space Stage, when the Grox are most likely to notice your presence. Pair stealth with strategic placement of colonies and outposts, avoiding direct borders with Grox territories. Remember, stealth isn’t just about hiding—it’s about buying time to build your strength.
Shields, on the other hand, are your active defense mechanism. The Grox are notorious for their aggressive fleets and advanced weaponry, making shields essential for protecting your ships and planets. Prioritize researching and upgrading shield technology to withstand their attacks. A well-shielded fleet can not only survive encounters but also retaliate effectively. Combine shields with weapon upgrades to create a balanced force capable of both defense and offense.
FTL technology is the game-changer in outmaneuvering the Grox. With faster-than-light travel, you can strike quickly, retreat safely, and manage multiple fronts efficiently. Focus on upgrading your FTL drive to reduce cooldown times and increase range. This allows you to launch surprise attacks on Grox colonies, disrupt their supply lines, and evacuate vulnerable systems before they can retaliate. FTL isn’t just about speed—it’s about strategic mobility.
The synergy of these technologies is where true mastery lies. Stealth keeps you hidden, shields keep you alive, and FTL keeps you one step ahead. For instance, use stealth to approach a Grox system undetected, deploy shielded ships to neutralize their defenses, and then use FTL to escape before reinforcements arrive. This combination of evasion, defense, and mobility turns the Grox’s strength into a liability, as their predictable aggression becomes a weakness against your adaptability.
In practice, allocate resources wisely. Research stealth first to avoid early conflicts, then invest in shields to prepare for inevitable encounters. Finally, prioritize FTL upgrades to gain the upper hand in both offense and retreat. By systematically advancing these technologies, you not only survive the Grox but also position yourself to challenge their dominance. The key is patience and strategic planning—turn their universe into your playground.
Are Laccaria Spores White? Unveiling the Truth About Their Color
You may want to see also
Frequently asked questions
The Grox are located in the center of the galaxy in Spore. To find them, you need to travel to the core of the galaxy map in the Space Stage.
The Grox are hostile and will attack on sight. It’s best to approach them with a well-equipped ship, high health, and defensive tools like shields or weapons.
Yes, you can avoid the Grox by staying away from the galactic core. Focus on exploring and interacting with other civilizations in the outer regions of the galaxy.
While challenging, you can defeat the Grox with a powerful ship, advanced weapons, and strategic planning. However, they are a formidable opponent, and defeating them is not required to complete the game.